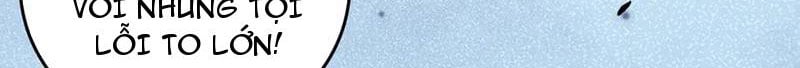
Bắt Đầu Kế Nhiệm Boss Hắc Long, Ta Vô Địch Chap 81 - Next Chap 82

Bắt Đầu Kế Nhiệm Boss Hắc Long, Ta Vô Địch - Chương 81
Nếu không xem được truyện vui lòng đổi "SERVER HÌNH" bên dưới
Sử dụng mũi tên trái ( ← ) hoặc phải ( → ) để chuyển chapter
Bình Luận (0)